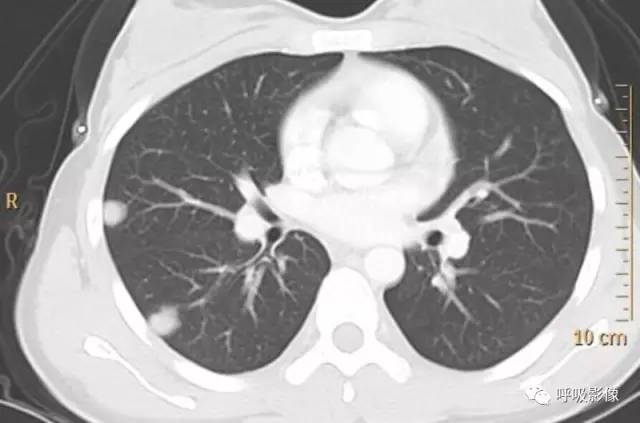
绒毛膜癌转移到脑,绒毛膜癌肺转移

三个案例,值得收藏!
作者丨张嵩
来源丨呼吸影像
案例一:





该病例为中国心胸医学影像论坛轮值病例
我当时回答如下:

诊断依据:此案例虽然是孤立性病变,但基本完全坏死,结合流产史,诊断绒毛膜癌肺转移。
最终结果:绒毛膜癌肺转移
下面我系统分析下这个病:
分析:绒毛膜癌是妊娠滋养细胞肿瘤(GTT)的一种。GTT包括侵袭性葡萄胎、绒毛膜癌和胎盘部位滋养细胞肿瘤,易早期发生血行转移,最常见的转移部位是肺脏(80%)。
注明:以下图片均由山东省肿瘤医院黄勇教授提供,特此感谢。
绒毛膜癌较侵袭性葡萄胎易发生转移。侵袭性葡萄胎肺部转移多以结节为主(图1),而绒毛膜癌肺部转移种类较多。

图1 女,31岁,侵袭性葡萄胎
那么绒毛膜癌肺部转移的影像多样性表现在哪里呢?
绒毛膜癌肺转移的影像特点为瘤细胞栓子到达肺部后滞留、浸润、生长、破坏、出血、炎症等的表现。CT典型表现为胸膜下单发或多发类圆形结节影及肺外周病变。
转移灶的影像早期可表现为不规则的小片状影或磨玻璃样阴影,逐渐增密、增粗,形成边缘不光滑的结节或肿块影,可伴出血,此时边缘毛糙,周围出现晕征、铺路石征等(图2)。
注意绒毛膜癌肺转移可以表现为单发。出血、晕征可以是早期表现。

图2 女,39岁 绒癌双肺转移伴肺内出血。可见肺内磨玻璃影和铺路石征。
随着β-HCG水平的变化,最终发展为边缘较为光滑、密度均一的结节或肿块影(图3),可有空洞(图4),肺门或纵隔淋巴结常无肿大。
图3 女,22岁 绒癌肺转移。表现为典型结节。

图4 女,26岁 绒癌肺转移。表现为结节、空洞,晕征可见。
简而言之:生殖系统肿瘤强化明显、坏死也明显。因为血供好的肿瘤,后期生长迅速,血供难以跟上。所以,生殖系统肿瘤血供丰富,容易强化,也容易坏死。
另外,上面讨论病例结合既往有无月经期咯血可除外子宫内膜异位症;无肺栓塞可除外抗磷脂抗体综合症。
注明:下面病例为黄勇教授确诊,我仅代为分析,特此声明。
案例二:
简单病史:女,43岁。咯血10余天。既往有子宫肌瘤切除病史。于山东省肿瘤医院查体,CT示:1.右侧附件区囊实性占位,同侧卵巢静脉显著增粗,考虑恶性肿瘤。2.双肺结节,考虑转移。3.宫体低密度灶,不除外子宫肌瘤。4.腹部、颈部扫描未见异常。子宫肌瘤病理切片会诊:子宫平滑肌瘤。盆腔附件包块穿刺活检细胞学检查示:查到可疑癌细胞。组织病理示:查见极少肿瘤细胞,考虑癌细胞。行紫杉醇联合卡铂化疗一疗程。




诊断: 绒毛膜癌肺转移。
诊断依据:中年女性,有咯血病史。既往有子宫肌瘤切除病史。CT示右侧附件区囊实性占位,同侧卵巢静脉显著增粗,考虑恶性肿瘤。盆腔附件包块穿刺活检细胞学检查查到可疑癌细胞。病理示查见极少肿瘤细胞,考虑癌细胞。
胸部CT示双肺多发结节影,强化明显,内见明显坏死,提示血供丰富。
转移瘤多具有原发肿瘤特点,本例转移瘤为生殖源性肿瘤,盆腔附件包块穿刺活检细胞学检病理均查见恶性肿瘤细胞,结合转移灶坏死、强化明显,需考虑绒毛膜癌可能。
胸部CT双肺多发结节影,强化明显,内见明显坏死,提示血供丰富,这是诊断关键。
治疗结果:更改化疗方案为DDP 40mg d1-3,BLM 15mg d1-4,VP-16 0.1 d1-5。化疗过程顺利。化疗3次后血HCG降至正常,继续化疗2疗程,血人绒毛膜促性腺激素:0.411 mIU/mL;B超示宫体前壁实质内见3.2*2.0cm高回声肿物,内探及丰富血流信号;胸部肿瘤消退明显。
行全子宫+双附件切除术,术后病理为子宫肌层内片状坏死伴纤维组织增生,炎细胞浸润,未见残留瘤细胞,符合化疗后改变。左右宫旁未见病变。增殖期子宫内膜。宫颈慢性炎。左右卵巢、输卵管组织。15天后复查人绒毛膜促性腺激素<0.100 mIU/mL,胸片检查示双肺转移瘤治疗后消失。化疗1疗程,方案为DDP40mg d1-3,BLM 15mg d1-4,VP-16 0.1 d1-5。
分析: 绒毛膜癌(简称绒癌)是源自妊娠绒毛滋养层上皮的高度侵袭性恶性肿瘤,少数可发生于性腺或其他组织的多潜能细胞,病因复杂,绝大多数与妊娠有关,多继发于葡萄胎,也可继发于流产、异位妊娠及早产或足月产后。20岁以下和40岁以上女性为高危年龄,偶尔发生于未婚妇女的卵巢称为原发性绒毛膜癌。发病危险因素有完全性葡萄胎史、种族、高龄产妇等。绒癌多发生在子宫,但也有子宫内未发现原发病灶而只有转移灶出现,本例符合此种情况,不除外转移瘤来源于卵巢可能。
绒癌临床表现为阴道不规则出血及转移灶引起的相关症状。绒癌实质上是滋养干细胞失去控制后的异常增生,造成原有的绒毛结构发生改变,由于其极强的破坏、侵犯血管能力,不断侵入子宫肌层、浸润溶解子宫内膜基质,因此早期便易出现血行转移。绒癌癌栓脱落后循静脉回流经右心进入肺动脉,可栓塞肺动脉小分支,绒癌细胞增殖侵透血管壁后,破坏肺组织,与血肿混合而成肺转移灶;侵透肺小静脉后,癌细胞经左心随体循环动脉转移到脑、肝等全身各脏。因此肺常是血行转移的第一站,跳跃肺的远处转移极为罕见。若未能有效控制肺转移,极易发生脑转移等远处转移,成为绒癌最常见的死亡原因。绒癌肺转移早期可无明显临床表现,最常见症状为咳嗽、咳痰,有时也可见咯血,严重者可有胸痛、胸闷、呼吸困难,甚至出现呼吸衰竭。大于60%绒癌患者确诊时已发生肺转移。
本例即因转移灶强化、坏死明显,结合患者有咯血症状,临床考虑绒癌,并行血β-hCG检查支持该诊断。绒癌的治疗原则以化疗为主,辅以手术、放疗、介入等综合治疗,绝大多数患者化疗后绒癌肺转移灶即可消失。本例行6次化疗后肺转移灶完全消失,β-hCG下降至正常,属完全缓解,符合净化转移,为原发灶的切除创造了条件。
什么是净化转移和转移的自发消失?
净化转移是指肺转移结节经有效化疗后其大小保持稳定不变或缩小,组织学检查显示结节坏死伴或不伴纤维化,无残存恶性细胞的证据。*丸睾**癌、绒毛膜癌、生殖细胞肿瘤及偶尔其他恶性肿瘤的肺转移经化疗后可发生此种情况。除组织学检查外,临床上很难判断是否属净化转移。肿瘤学标记物如人绒毛膜促性腺激素(β-HCG)、甲胎蛋白(AFP)的检测有助于确定其活性。PET检查结节的生物学活性也有助于鉴别诊断,必要时可行穿刺活检。
绝少数情况下,原发瘤经手术切除、放疗或化疗后,肺转移瘤可自发性消失,其机理至今不明。
该例充分体现了临床医生熟知疾病影像特征的重要性,体现了医生自身的价值。
案例三:
简单病史:女,35岁。查体发现肺部占位。胸部CT;右肺中叶外侧段近胸壁处圆形病变,边缘光滑,无毛刺, 增强扫描可见强化。


诊断: 肺良性肿瘤或孤立性转移瘤
诊断依据:青年女性,右肺中叶结节影,边缘光滑,密度均匀,无明显分叶、毛刺,临近胸膜无受累、肋骨无压迹,不符合肺恶性肿瘤诊断;患者无症状,不符合感染性疾病;病变密度均匀,内无坏死,无卫星灶,不符合结核球诊断。综合考虑肺良性肿瘤或孤立性转移瘤可能性大,病变位于胸膜下,孤立性转移瘤需考虑。病变增强扫描可见血管样强化,提示原发瘤血供丰富,最终病理为绒毛膜癌肺转移。
分析:恶性肿瘤的肺转移率高达40%-50%,80%-90%为多发转移,约10%-20%为局限性或孤立性病灶,影像诊断较为困难。某些原发瘤易造成孤立结节肺转移,包括结肠癌(特别是直肠乙状结肠区)、肉瘤(特别是起源于骨的肉瘤)、肾癌、膀胱及*丸睾**恶性肿瘤、乳腺癌以及恶性黑色素瘤等。
孤立性肺转移瘤多为肺血行转移的一个阶段,因为肺血供特点,其分布是右肺略多于左肺、下肺多于上肺、几乎都分布于肺野外带及胸膜下肺组织。
孤立性肺转移瘤受血行转移过程及原发肿瘤的病理及生物学行为双重影响,表现形式多样,和众多的肺内孤立性结节鉴别较为困难。
孤立性肺转移并不少见,希望大家有所认识。 今天分享下绒癌的影像诊断、净化转移、孤立性肺转移,不到之处,敬请指正。